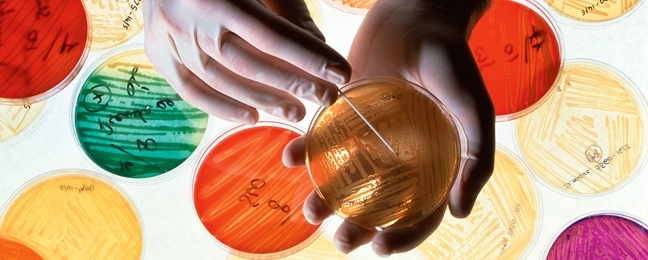

Od jakiegoś czasu przestałem cieszyć się z życia, jakby coś zabierało mi tlen. Obniżony nastrój i słaba motywacja do czegokolwiek sprawiała, że nawet ciężko było mi regularnie jeść w ciągu dnia – a co dopiero pójść na trening i dostarczyć sobie tej pozytywnej dawki zmęczenia, czytaj: endorfin. Na pewno znacie to uczucie, kiedy nic wam się nie chce, a w momencie, w którym macie coś ważnego do zrobienia, nagle wszystko inne staje się priorytetem – taki stan rozproszenia, trudno się skupić. Dodatkowo kłócicie się cały czas ze swoją drugą połówką (a może już ćwiartką?) i nagle wasza satysfakcja z życia w skali od 1 do 10, z mocnej 8 spada na mizerne 3.
Teraz śmiało mogę się poczuć jak w grupie wsparcia i napisać:
Cześć, jestem Piotr, od 47 dni regularnie biorę lodowate prysznice, a zaczęło się to tak…
Właśnie, jak to się zaczęło? Myślę, że kontekst pozwoli nam trochę przybliżyć cały obraz sytuacji. Jak wszyscy wiemy, najtrudniej jest zacząć, a szczególnie coś tak niekomfortowego i nienaturalnego dla nas w tych ciepłych i wygodnych czasach jak lodowaty prysznic.
Na pewno każdy z nas usłyszał kiedyś stwierdzenie typu „wylej sobie zimny kubeł na głowę” lub „weź zimny prysznic”. Zastanawialiście się, o co z tym chodzi? Ja poddałem to głębszej refleksji. Potraktowaliśmy te słowa z dużym dystansem i umówmy się – żadne z nas nie wylało sobie tego kubła na głowę. Pozwólcie, że pokażę wam, jak zimny prysznic oddziałuje na nasze życie.

Zadbaj o jakość swojego życia! Dzięki tym książkom zrozumiesz, co dzieje się w Twoim życiu, zauważysz to, co warto zmienić i dokonasz tej zmiany. Promocja na tę kolekjcję kończy się już niebawem! Zamów już teraz TUTAJ.
Pierwszy raz
Poranek, 8 rano. Otwieram oczy, chwytam za telefon i rozpoczynam rytuał milenialsa – Fejsbuk, Instagram, mail i Snapchat. Odchodząc od głównego tematu, muszę przyznać, że taki poranny przegląd cudzego życia całkiem nieźle pobudza. Widzimy emocje u innych, które siłą rzeczy wzbudzają uczucia i w nas. Zaczynamy działać. Niestety szybko zdaję sobie sprawę, że od wczoraj nic się nie zmieniło. Przez pierwsze 5 minut chciałem zabrać się za rzeczy naprawdę ważne, ale ochota odeszła wraz z rozpraszającymi newsami na Fejsbuku. Zaczynam myśleć o kiepskich relacjach, mam ochotę wyrzucić telefon przez okno. Poziom satysfakcji znów nie przekracza marnej trójki. Tak użalając się nad sobą i mamrocząc n...

Dołącz do 50 000+ czytelników, którzy dbają o swoje zdrowie psychiczne
Otrzymuj co miesiąc sprawdzone narzędzia psychologiczne od ekspertów-praktyków. Buduj odporność psychiczną, lepsze relacje i poczucie spełnienia.